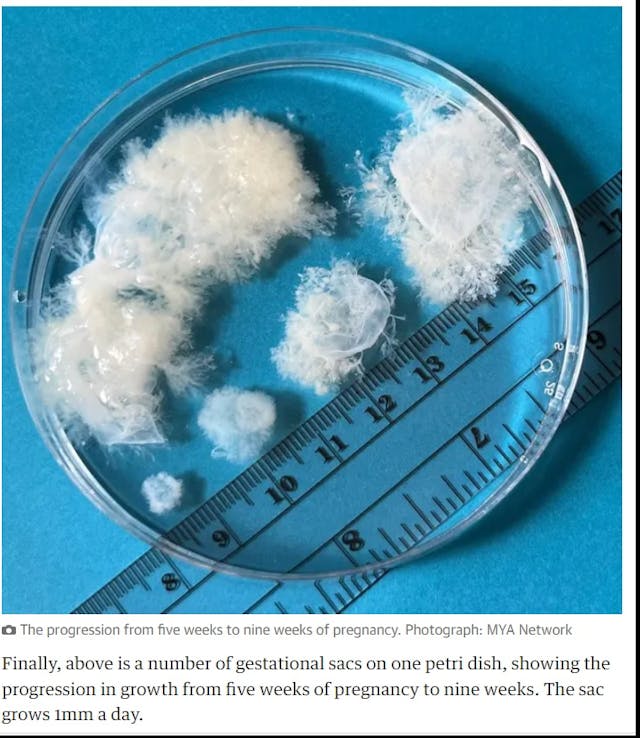

(Live Action) — Planned Parenthood Florida Action recently attempted a so-called “fact check” on Live Action’s prenatal development video, “Meet Baby Olivia,” and claimed the video is inaccurate and misleading.
But this supposed fact check is a flop; “Baby Olivia” uses the same scientifically accurate information distributed for years by National Geographic in an award-winning prenatal development video created by a non-partisan organization, the Endowment for Human Development (EHD).
Planned Parenthood, with its history of propaganda used to deceive women into killing their preborn children, truly doesn’t have a leg to stand on.
Key takeaways
- Planned Parenthood has tried to “fact check” Live Action’s “Meet Baby Olivia” video – an effort which, as usual, relies on falsehoods, misrepresentations, fallacies, and even misleading photographs.
- Planned Parenthood claims that showing the “Baby Olivia” prenatal animation is indoctrination; yet it fails to show how the information presented is inaccurate. In addition, the video does not discuss abortion.
- Planned Parenthood does its best to dehumanize preborn humans by attempting to discredit documented, scientific information; this should be unsurprising, given that killing these preborn humans is quite profitable for the corporation.
READ: GOP congressmen call for investigation into FDA officials who approved new abortion drug
The backstory
Planned Parenthood has been up in arms over “Baby Olivia,” Live Action’s scientifically accurate computer-animated video detailing human prenatal development. Since its creation in 2021, “Baby Olivia” has been the impetus for introducing prenatal development education into sex ed classes in multiple states.
It wasn’t until 2024 that Planned Parenthood’s friends in the media went into a tailspin, attempting to debunk the video as fake because, frankly, sex ed classes are where Planned Parenthood targets the next generation with pro-abortion ideology. It’s been promoting its questionable agenda to children under the guise of sexual education for years. The introduction of “Baby Olivia” and similar materials into state school systems signaled a threat to Planned Parenthood’s future abortion income and ideological goals.
In Planned Parenthood Florida Action’s attempt to undermine the video, it turned to its usual biased sources.
The details
What are Planned Parenthood’s claims about “Baby Olivia”?
- It doesn’t like that Baby Olivia measures embryonic and fetal age based on the date of fertilization/conception.
- It claims the “fetal heartbeat” is a “myth.”
- It uses intentionally deceptive and debunked photography to claim embryos are nothing more than tissue.
- It argues that EHD’s (and, thereby, National Geographic’s) description of life inside the womb “contradicts clinical research.”
- It argues that a low survival rate for babies born before 23 weeks means they aren’t viable.
- It claims Baby Olivia is “inaccurate” without pointing out any specific inaccuracies.
- It claims that scientific facts about human development are “dangerous indoctrination.”
Live Action created “Baby Olivia” using human development information from EHD (whose prenatal development DVD is distributed by National Geographic) for use as an education tool. EHD is a non-profit, non-partisan organization whose mission is to apply “the science of human prenatal development … as an indispensable and unique way to improve children’s health, enhance their development, and prevent certain birth defects and chronic diseases.”
It vows to be neutral on controversial issues like abortion, making it an unbiased source for “Baby Olivia.”
Dating a pregnancy based on fertilization
Planned Parenthood claims that tracking Baby Olivia’s development based on the date she came into existence (fertilization) rather than by the date of a woman’s last menstrual period (LMP) – which is an estimated two weeks earlier – is “inaccurate” and “not how doctors measure pregnancy.”
Yet, according to My Health Alberta, it “is possible for gestational age to be inaccurate by up to 2 weeks, even with an accurate LMP date.” And according to Medscape, “Conceptional age (CA) is the true fetal age and refers to the length of pregnancy from the time of conception” (emphasis added).
READ: EPA investigating ways to test abortion pill chemicals in water supply
When the human heart begins pumping blood
Planned Parenthood claims that the early heartbeat of a preborn child is a myth “made by anti-abortion extremists to justify six-week abortion bans.” It claims that “Baby Olivia” is wrong in stating that a “‘fetal heartbeat’ can be detected at six weeks (or three weeks in this video because of inaccurate timing.)”
First of all, what the “Baby Olivia” video actually states is this: “At 3 weeks and 1 day, just 22 days after fertilization, Olivia’s heartbeat can be detected.” (This would be the equivalent of 5 weeks and 1 day, if adding two weeks for LMP or gestational age.)
Peter J. Ward, Ph.D., a professor of anatomy, explained, “The heart, to do its job, has to be able to pump, and it starts pumping fairly early on – about day 23 of development.… At this point, we’ve got a nice flow of blood already set up through the heart.” (emphasis added)
Likewise, physician and medical educator Dr. Mobeen Syed explained, “[The] heart is the very first organ that starts developing and it is the first organ that reaches a functional state. Can you imagine that the heart reaches a functional state even before its own development completes? When the heart is in the form of a tube, even then it is pulsating and it is beating and it is pumping blood.” (emphases added)
The video clearly states that the heartbeat can be “detected” at just over three weeks (five weeks LMP), which is accurate. But Planned Parenthood inexplicably claims that based on Baby Olivia’s description (which, by the way, is given at the same time the video shows a pulsating light within the developing embryo), “Based on this description [‘At 3 weeks and 1 day, just 22 days after fertilization, Olivia’s heartbeat can be detected’], you might imagine a heart-shaped organ beating, but this isn’t the case at all” (emphasis added).
Based on what description, exactly? The use of the word “heartbeat“?
READ: Spanish government demands registry of doctors who object to committing abortion
Planned Parenthood continued: “At this stage, all an ultrasound can detect is ‘a little flutter in the area that will become the future heart of the baby,’ according to Dr. Saima Aftab … This flutter happens when the cells that will eventually become the ‘pacemaker’ of the heart begin to fire electrical signals.” Yes, these specialized cardiac cells already function, even before the heart is fully formed.
Take a look at this amazing embryoscopy of the two-chambered heart at four-and-a-half weeks post-fertilization:
Medical News Today states, “The heart of an embryo starts beating at about week 5 of pregnancy [about 3 weeks post-fertilization]. It may be possible to detect the heartbeat at this point using vaginal ultrasound.”
While the heart does not yet have four chambers at this point, it is functioning and pumping blood.
Intentionally deceptive photography
Planned Parenthood claims that the embryonic Baby Olivia looks nothing like a real embryo. To try to prove this false claim, it uses heavily altered and debunked photos from the biased MYA Network, which even abortion supporters decried as ridiculously false in 2022 when The Guardian and Buzzfeed reposted them.
The image it takes from MYA Network (an organization with the goal of “normalizing abortion care”) is an image of an embryonic sac with the embryo removed.
Below is the image of “tissue” or “embryonic sac” from MYA Network.
“The images … are clearly intentionally misleading. They state that they are pictures of gestational sacs, ignoring the inconvenient fact that in pregnancy, the gestational sac surrounds the embryonic or fetal human being – which have clearly been removed before these photos were taken,” explained Dr. Christina Francis, a board-certified OB/GYN and board member of the American Association of Pro-Life OB/GYNs.
In fact, the images even appear to contradict embryonic images published by abortion groups like the National Abortion Federation (NAF), the pro-abortion American College of Obstetrics and Gynecologists (ACOG), and even Planned Parenthood itself.

READ: Texas AG Ken Paxton announces 8 more arrests connected to illegal abortion operation
This screenshot from EHD’s in-utero video footage of a human at six weeks and six days looks incredibly similar to “Baby Olivia” in her sixth week of life.
Here is the screenshot from EHD:

And here is one showing “Baby Olivia” at 6 weeks:

Baby Olivia vs. ‘clinical research’
Planned Parenthood also took issue with Baby Olivia “playing in the womb, moving her body, and exploring her environment” at 11 weeks post-fertilization (13 weeks LMP).
It claims that embryos can’t “startle, hiccup, stretch, and [have] head or eye movements” until “15 gestational weeks.”
But any woman who has seen an ultrasound of her live baby prior to 15 weeks (17 weeks LMP) has seen her baby move and sometimes even hiccup. And the “clinical research” Planned Parenthood cites is more than a decade old.
Premature babies
Planned Parenthood tries to debunk Live Action’s statement that “around 20 weeks, with a lot of help, babies have survived outside the womb.” This would be 22 weeks LMP/gestational age.
The truth is that babies born at 21 weeks LMP have survived, as documented by the Guinness Book of World Records. To argue against the survivability of these premature babies, Planned Parenthood turns to the pro-abortion ACOG, which claims that “fetal viability depends on many complex factors, of which gestational age is only one.”
This is a claim that abortionists created to skirt laws protecting preborn children from abortion at “viability.” By claiming that viability is a moving target, unique to each preborn child, an abortionist can abort a baby after 21 weeks regardless of the law if he deems that child non-viable.
Beyond this, Planned Parenthood argues that even if babies can survive such a preterm birth, it doesn’t matter because the number who do survive only amounts to about “6%” of those born before 23 weeks (which could include babies born at any point prior to 23 weeks) and only “1% “do not have “neurodevelpomental impairment” – as if the 5 percent who do are not worth saving.
When looking at research specifically for babies born at 23 weeks LMP (21 weeks post-fertilization), there is a 55 percent survival rate, according to Stanford researchers. Stanford found that of babies born between 22 and 26 weeks LMP (20 to 24 weeks post-fertilization), half of those who survived had “no or minimal neurodevelopmental impairments” at 2 years old.
READ: 51 senators urge Trump admin to stop allowing abortion pills in the mail
Baby Olivia is backed by data
Planned Parenthood notes that Fargo Public Schools stopped using the Baby Olivia video after a teenage student claimed it was misleading. That student’s mother described the video as “anti-choice” – revealing a pro-abortion bias.
Baby Olivia was removed from the school ultimately because there was no proof of “the effectiveness of the curriculum resource.” But as a new curriculum resource, it would take more than a matter of months to prove any “effectiveness” of a video that is meant to educate on prenatal development.
Another reason given for its removal was that it was only used in a “single classroom” or course, and there was also the claim that it “contains significant portions of untrue information, inaccurate facts, and/or faulty premises.” Two of the supposed issues were that “the video does not contain all major organ development; it states that the heartbeat is heard at three weeks” (emphasis added).
But no argument is made claiming that the organ development that is shown in Baby Olivia is inaccurate. It does not logically follow that, just because Baby Olivia doesn’t show more information about all organ development, it is misleading.
As for the heartbeat being “heard at 3 weeks,” Baby Olivia doesn’t even claim this at all. It uses the term “detected” – which, again, is entirely accurate.
Planned Parenthood claims fetal development is ‘indoctrination’
To wrap up the “fact check,” Planned Parenthood claims that the “video fictionalizes fetal development.” It fails to explain further, but again, National Geographic distributes the same development facts from EHD, on which Baby Olivia milestones are based.
Planned Parenthood also claims the video “downplays the risks of pregnancy,” quoting abortionist Dr. Daniel Grossman (who financially profits from abortions). In a puzzling comment, he states, “There is very little mention of the woman in whose body the embryo is developing, including how she may feel about the pregnancy and how it may be affecting her health.”
Nothing about the woman’s health or the risks of pregnancy – and certainly not a woman’s “feelings” about the pregnancy – changes any of the facts about how human beings develop in the womb.
READ: Quebec moves to recognize ‘right’ to abortion in proposed constitution
Grossman, as an abortionist, would surely prefer to ignore and downplay the humanity of the child in the womb, as most abortionists do; however, complaining that an animated video about how a human develops in the womb doesn’t discuss the woman’s “feelings” surely wins the prize for one of the most obtuse comments about Olivia to date.
Facts are not indoctrination. What is indoctrination is the sex ed that Planned Parenthood gives to students, which fails to include information about the developing human being who may result from sex, instead choosing to focus on pornographic imagery, descriptions of sexual techniques, and information on BDSM and role-playing. And let’s not forget that one of its sex ed partners has even promoted the abortion pill to 10-year-olds.
The bottom line
Planned Parenthood’s goal is to dehumanize the preborn child, prioritize feelings over facts, and convince children (without proof) that “Baby Olivia” is propaganda, all to build a future client base to continue financially profiting from abortion.
When women know the truth – that their babies are not mere clumps of cells – they often choose life over abortion, which means Planned Parenthood loses money. This is likely the only reason that it is hellbent on convincing the world that preborn babies aren’t human beings.
Reprinted with permission from Live Action.
















